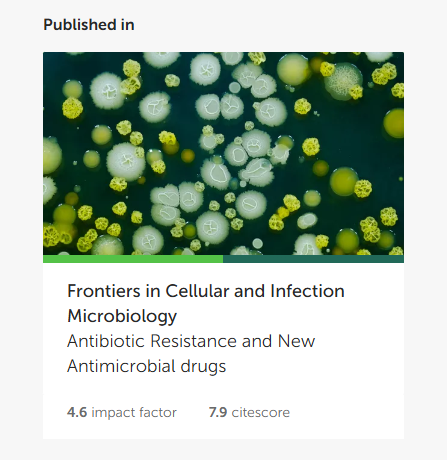

Academics from the Arabian Gulf University Contribute to Global Book on Microbiology of Infections and AMR
Arabian Gulf University
24 Mar, 2025
A number of faculty members at the College of Medicine and Health Sciences at the Arabian Gulf University (AGU), namely Dr Mohammad Shahid, Dr Nayeem Ahmed, and Dr Ronni Moi Joji, have participated in the preparation of a global electronic scientific book focused on the microbiology of infections.
This book aims to highlight the latest research and scientific developments in the field of clinical microbiology, with a particular emphasis on antimicrobial resistance (AMR) and its impact on public health. Furthermore, it discusses various mechanisms of microbial resistance, in addition to innovative strategies to combat infections, including nanomaterials, antibiotic adjuvants and therapies targeting biofilms.
The book has been published by Frontiers, a renowned global publishing house classified among the top quarter of leading peer-reviewed scientific databases worldwide (Q1). The publisher estimates that its scientific publications reach an impressive exposure of approximately three billion views and around nine million citations.
Moreover, the researchers involved in the book confirmed that antimicrobial resistance poses a significant global health threat, necessitating a comprehensive multidisciplinary approach, such as the "One Health" approach, which integrates human, animal, and environmental health efforts to address this crisis.
This book represents a valuable scientific contribution that enriches the medical field, enhances awareness of the risks associated with antimicrobial resistance, and proposes sustainable solutions to minimise its spread, thereby promoting public health at both regional and global levels.
